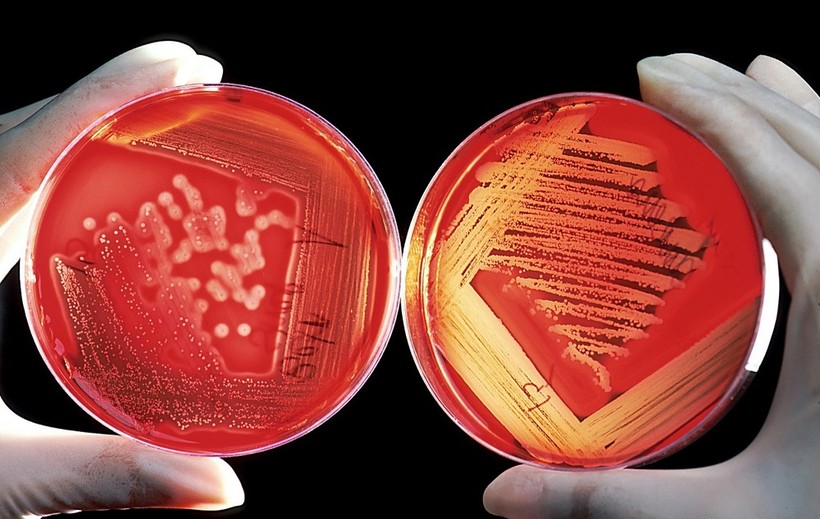

[일요주간 = 노현주 기자] 영·유아 등 면역력이 약한 계층이 주로 섭취하는 식품에서 기준치를 초과하는 세균 등이 검출됐다.
식품의약품안전처는 지난달 17~23일 ‘이유식 및 영·유아용’으로 표시해 판매하는 과자류와 음료류 등을 제조하는 업체 총 574곳을 점검해 식품위생법을 위반한 7곳을 적발했다고 10일 밝혔다.
이번 점검은 17개 지방자치단체와 함께 영·유아, 환자 등 면역력이 취약한 계층이 주로 섭취하는 식품의 안전관리를 위해 진행됐다.
|
| ▲ (사진=픽사베이) |
주요 위반 내용은 ▲자가품질검사 미실시(2곳) ▲유통기한 경과 제품 조리 목적 보관(1곳) ▲생산일지 미작성(1곳) ▲보관기준 위반(1곳) ▲건강진단 미실시(1곳) ▲위생모 미착용(1곳) 등이다.
업체는 부산 나래푸드원(보존 및 유통기준 위반, 칼·도마 미구분 사용), 부산 황토농원(위생모 미착용), 부산 ㈜대광 에프앤씨(생산작업일지 미작성, 보고대상 이물 미보고), 경기도 광주 아기랑(자가품질검사 미실시), 전남 농업회사법인 녹색식품(자가품질검사 미실시), 경기도 아가얌얌 고양삼송점(유통기한 경과 제품 조리목적 보관), 경북 포항 맘마앤쿡(건강진단 미실시) 등이다.
적발된 업체에 대해서는 관할 지자체가 행정처분 등을 조치하고, 3개월 이내에 다시 점검해 위반사항 개선 여부를 확인한다.
또 점검업체 제품을 포함해 시중에 유통 중인 이유식 및 영·유아용 표시식품 131건을 수거해 식중독균 등을 검사한 결과, 2건에서 세균수 기준을 초과해 즉시 폐기 등 조치했다.
2건은 울산 맘앤맘마 ‘아욱한우 미음’, 제주 마미포유 ‘흑우 강황쌀 브로콜리’ 등이다.
식약처 관계자는 “앞으로도 건강 취약계층이 이용하는 식품에 대해 지속적인 지도·점검과 수거·검사 등을 통해 안전관리를 강화할 것”이라고 말했다.
'시민과 공감하는 언론 일요주간에 제보하시면 뉴스가 됩니다'
▷ [전화] 02–862-1888
▷ [메일] ilyoweekly@daum.net
[저작권자ⓒ 일요주간. 무단전재-재배포 금지]






























































![부산 덕포동 중흥S클래스 건설현장서 화재 발생...검은 연기 치솟아 [제보+]](/news/data/20220901/p1065590204664849_658_h2.jpg)
![[포토] 제주 명품 숲 사려니숲길을 걷다 '한남시험림'을 만나다](/news/data/20210513/p1065575024678056_366_h2.png)
![[포토] 해양서고 예방·구조 위해 '국민드론수색대'가 떴다!](/news/data/20210419/p1065572359886222_823_h2.jpg)
![[언택트 전시회] 사진과 회화의 경계](/news/data/20210302/p1065575509498471_939_h2.jpg)











